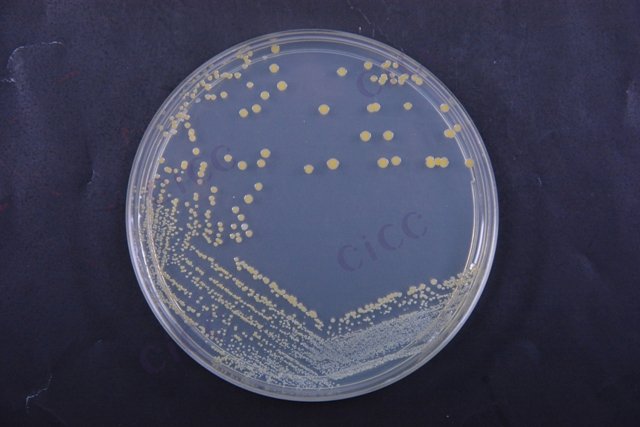
金黄色葡萄球菌 Staphylococcus aureus CICC 10306 Staphylococcus aureus

金黄色葡萄球菌 Staphylococcus aureus CICC 10306 Staphylococcus aureus
-
金黄色葡萄球菌 Staphylococcus aureus CICC 10301 Staphylococcus aureus
CICC 10301 | 见证书
-
金黄色葡萄球菌 Staphylococcus aureus CICC 10307 Staphylococcus aureus
CICC 10307 | 见证书
-
金黄色葡萄球菌 Staphylococcus aureus CICC 10473 Staphylococcus aureus
CICC 10473 | 见证书
-
金黄色葡萄球菌 Staphylococcus aureus CICC 10001 Staphylococcus aureus
CICC 10001 | 见证书
-
金黄色葡萄球菌 Staphylococcus aureus CICC 10145 Staphylococcus aureus
CICC 10145 | 见证书
-
金黄色葡萄球菌 Staphylococcus aureus CICC 10201 Staphylococcus aureus
CICC 10201 | 见证书
-
金黄色葡萄球菌 Staphylococcus aureus CICC 10786 Staphylococcus aureus
CICC 10786 | 见证书

说明书下载: 菌种说明书 打管说明书
您正在浏览的产品:金黄色葡萄球菌 Staphylococcus aureus CICC 10306
手机版:金黄色葡萄球菌 Staphylococcus aureus CICC 10306
本公司销售的所有产品仅供实验科研使用,不用于人体及临床诊断。
2. 阴性对照:无菌生理盐水;
3. 每批次实验需包含10%平行样,结果偏差不得超过±15%[6][7]。
2. 增菌培养:7.5%氯化钠肉汤36℃±1℃培养18-24h;
3. 分离培养:血平板(观察溶血)和Baird-Parker平板(黑色菌落)同步划线;
4. 凝固酶试验:兔血浆凝固法验证[6][7]。
2. 耐热核酸酶试验可作为凝固酶试验的替代方法;
3. 食品加工环境样品需增加表面涂抹采样步骤[6][4]。
以上信息仅供参考,请以相应标准的原文为准!